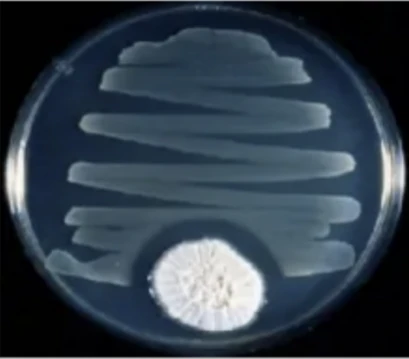
image.

人类与细菌战斗源远流长、从未停止且愈演愈烈。至今,细菌的变化多端也正在一次又一次的冲击着我们的防线。
在一千多年的今天,那里没有青霉素、没有链霉素、没有金霉素、没有土霉素更没有万古霉素这些如今看起来平常的抗菌物质,有只有人孤孤单单的免疫系统与外界庞大的细菌部队抗衡。细菌在那个时间肆意妄为、毫无忌惮,即使是一个小小的伤口也会夺取一条鲜活的生命。细菌性感染所引起的肺炎、脑膜炎、脓肿、败血症更是像“绝症”一样,将患者打上死亡的印记。
第一次世界大战期间,作为英国皇家陆军医疗队队长的他目睹细菌从受伤战友感染的伤口一步步侵入血液却无能为力。作为一个医生,他不但不能减轻丝毫自己战友的痛苦,而且还要眼睁睁看着昔日和他同窗的战友一步一步跨过奈何桥,投入死神的怀抱。他,无力但心如刀绞。
他,是谁?他就是我们的主人公:亚历山大·弗莱明(Alexander Fleming)。
一生坎坷却几多幸运
亚历山大·弗莱明(Alexander Fleming)在1881年8月6日,出生于苏格兰基马尔洛克附近的洛克菲尔德。是一个苏格兰低地农民的后裔,自小家境贫寒。7岁时,其父亲不幸去世。随后,家境更加贫寒,生活拮据。
13岁他随其兄汤姆(开业医师)去伦敦做做工。
1901年,他20岁的时候,他的一个未婚舅舅去世,留下了一笔较为可观的遗产,他分得了250英镑。其兄汤姆建议其善用这笔财富,建议他去学习医学。于是,在7月,他通过16门功课的考试,获得进入伦敦大学圣玛丽医学院的资格,并这笔钱用于医学的学习。
1906年他从医学院顺利毕业。在当时的情况下,学术权威是不支持自己的助手按照自己的兴趣进行独立的科学研究,但赖特却允许他的助手做自己的研究。于是弗莱明成为了莱特的助手。他开始独立进行对痤疮进行免疫接种的研究,并改良梅毒繁琐的检测程序。在伦敦几乎只有他有能力为梅毒患者注射最新的治疗药物——六零六。

弗莱明正在圣玛丽医学院的实验室做实验
他也成为当时少数掌握静脉注射的医生,这一切都为他带来了学术上的初步声誉。当然他也为脱离莱特的研究范围,在其指导下做了有关吞噬细胞、调理素、伤寒菌等一系列的研究工作。
其后,一战爆发,莱特率他的研究小组奔赴前线,研究疫苗是否可以防止感染。这给了弗莱明一个很难得的系统学习致病菌的机会。在那里他还验证了自己的想法,在高含氧的组织中,伴随着氧气的耗尽,将有利于厌氧微生物的生长。还证明了用杀菌剂消毒创伤的伤口,事实上并未起到很好的作用,细菌没有真正被杀死,反倒把人体吞噬细胞杀死了,伤口更加容易发生恶性感染。同时,他还做了历史上第一个院内交叉感染的研究。

弗莱明
在第一次世界大战期间,他目睹了战友受细菌感染而死亡,自己却无能为力。于是,他决定回到伦敦进行细菌的研究。
1918年他返回圣玛丽医学院,加紧进行细菌的研究工作。1922年他因为对着培养基打了一个喷嚏,发现了体液中有一种叫“溶菌酶”的物质,并发表了《皮肤组织和分泌物中所发现的奇特细菌》的报告。

弗莱明正在圣玛丽医学院做实验
1929年弗莱明在实验培养的过程中意外培养出了青霉菌并在《不列颠实验病理学杂志》上,发表了《关于霉菌培养的杀菌作用》的研究论文,但未被人们引起注意。弗莱明指出,青霉素将会有重要的用途,但他自己无法发明一种提纯青霉素的技术,致使此药十几年一直未得以使用。
1939年,在英国的澳大利亚人瓦尔特·弗洛里和德国出生的钱恩,重复了弗莱明的工作,证实了他的结果,然后提纯到了青霉素,1941年给病人使用成功。在英美政府的鼓励下,很快找到大规模生产青霉素的方法,1944年英美公开使用青霉素。1945年后青霉素遍及全世界。
与此同时,1945年弗莱明、弗洛恩和钱恩共同获得诺贝尔生理或医学奖。
1943年弗莱明成为英国皇家学会院士,1944年被赐予爵士。1915年弗莱明结婚,儿子是一名普通医生。1949年夫人去世。1953年再婚。1955年3月11日逝世,葬于圣保罗大教堂。
科普小知识①
青霉素抑制细菌的原理:青霉素是一种β-内酰胺类抗生素。这类抗生素化学结构中均有一个β-内酰胺环和一个含有硫的杂环。青霉素能够与细胞表面的青霉素结合蛋白结合,阻止某些酶发挥作用,从而抑制细胞合成粘肽,而后者正是细胞壁的主要组成部分。换句话说,青霉素正是通过破坏细菌的细胞壁而发挥抗菌作用。人体细胞并无细胞对人危害较小。
“奇特细菌”——溶菌酶的发现
1921年,弗莱明刚发现青霉素不久,在一次紧张而又深入的研究工作过程中,正值隆冬,实验室内很冷,他不幸患上了重感冒,不断流清鼻涕。在他培养一种新的黄色球菌时,他索性取了一点鼻腔粘液滴在固体培养基上。第二天发现在清鼻涕四周出现了抑菌环。两周后,当弗莱明在清洗前最后一次检查培养基时,发现一个有趣现象。培养基上遍布球菌的克隆群落,但粘液所在之处没有,而稍远的一些地方,似乎出现了一种新的克隆群落,外观呈半透明如玻璃般。弗莱明一度认为这种新克隆是来自他鼻腔粘液中的新球菌,还开玩笑的取名为A.F(他名字的缩写)球菌。而他的同事Allison,则认为更可能是空气中的细菌污染所致。很快他们就发现,这所谓的新克隆根本不是一种什么新的细菌,而是由于细菌溶化所致。他再用眼泪来试验,结果比鼻涕的效果更好。为了收集更多的眼泪作试验,他动员邻居的孩子们为他收集眼泪。他和他的助手使用柠檬皮的汁来刺激眼睛,然后小心地收集每一滴眼泪。经过他一系列的研究,发现人体的分泌物如唾液、泪液、呼吸道和消化道分泌物,甚至人的皮肤、毛发、指甲内都可发现此种抑菌物质。他们发现,热和蛋白沉淀剂都可破坏其抗菌功能,于是他推断这种新发现的抗菌素一定是种酶。当他将结果向赖特汇报时,赖特建议将它称为溶菌酶,于是他把这种物质命名为“来沙仁”(Lysozeme)意译为溶菌酶。“Lysczeme”由拉丁文Lyso-(溶解)+希腊文Zy-mē(酶)构成。示意此物质是可以溶解细菌的酶。把最初的那种细菌如今被称为滕黄微球菌。
1922年1月,他们发现鸡蛋的蛋清中有活性很强的溶菌酶,这才解决了溶菌酶的来源问题。1922年稍晚些的时候,弗莱明发表了第一篇研究溶菌酶的论文。弗莱明和他的助手,对新发现的溶菌酶又做了持续7年的研究,但结果让人失望,这种酶的杀菌能力不强,且对多种病原菌都没有作用。

目前药用的溶菌酶是从鲜鸡蛋清中提取为一种能分解粘多糖的多胀酶,具有抗菌、抗病毒、止血、消肿及加快组织恢复功能等作用。
医学诺贝尔之路:抗生素时代
1928年9月3日,度假归来的英国科学家亚历山大·弗莱明在走进实验室的那一刻,绝无想要做出震惊世界的发现的心理准备。此前,弗莱明一直在进行金黄色葡萄球菌的研究。金葡菌是一种常见的致病菌,能够引起多种感染。曾有论文报告称金葡菌经过长时间的培养可能产生变异的菌株。弗莱明试图验证上述观点。于是在度假前,弗莱明并未清洗自己的细菌培养基,而是将它们堆放在室内,打算回来之后再作最后一次观察。
科普小知识②
金黄色葡萄球菌的基本知识:典型的金黄色葡萄球菌为球形,直径0.8μm左右,显微镜下排列成葡萄串状。金黄色葡萄球菌无芽孢、鞭毛,大多数无荚膜,革兰氏染色阳性。金黄色葡萄球菌的致病力强弱主要取决于其产生的毒素和侵袭性酶(如:溶血毒素:外毒素,分α、β、γ、δ四种,能损伤血小板,破坏溶酶体,引起肌体局部缺血和坏死;杀白细胞素:可破坏人的白细胞和巨噬细胞;血浆凝固酶:该酶使血液或血浆中的纤维蛋白沉积于菌体表面或凝固,阻碍吞噬细胞的吞噬作用。葡萄球菌形成的感染易局部化与此酶有关;肠毒素:金黄色葡萄球菌能产生数种引起急性胃肠炎的蛋白质性肠毒素,分为A、B、C、D、E及F五种血清型。肠毒素可耐受100℃煮沸30min而不被破坏。它引起的食物中毒症状是呕吐和腹泻)。金黄色葡萄球菌是人类化脓感染中最常见的病原菌,可引起局部化脓感染,也可引起肺炎、伪膜性肠炎、心包炎等,甚至败血症、脓毒症等全身感染。
1928年9月,度假归来的弗莱明发现他之前放在实验室角落的细菌培养皿中,有一只竟长出了一团青绿色的霉毛。显然,这是某种天然霉菌落进去造成的。(据说,是从楼上一位正在研究青霉菌的房间飘落下来的)。弗莱明正想把这发了霉的培养物倒掉,突然产生了一个念头:把它拿到显微镜下去看看。这一看不要紧,结果弗莱明发现,在霉菌周围,原本生长旺盛的葡萄球菌竟然都被杀死了。
被青霉菌污染的培养基
青霉菌生长的培养基
这个现象深深吸引了弗莱明。这是不是他梦寐以求,已追寻了好几年的葡萄球菌的克星呢?弗莱明立即动手大量培养这种青绿色的霉菌,将培养液过滤,滴到葡萄球菌中去,结果葡萄球菌在几小时之内全部死亡。将滤液冲稀800倍居然仍能杀死葡萄球菌。经过反复试验,弗莱明证实是青霉菌分泌出的某类化学物质,可以在几小时内导致周围的葡萄球菌死亡并溶解。弗莱明还不清楚这类物质究竟是些什么,于是根据他培养的霉菌种类——青霉菌(Penicillium)把该物质命名为盘尼西林(Penicillin),也就是青霉素。接下来,他又做了病理试验,把青霉素注入小白鼠体内,结果什么影响也没有,证明青霉素对动物无毒害。他又在家兔的眼睛里滴入这种液体,也没有发现异常现象。

弗莱明正在观察青霉菌
1929年6月,弗莱明把自己的发现写成论文,发表在英国的《实验病理学》季刊上。然而在那个时代,青霉素虽然能杀死细菌,但其具体有效成分都还没弄明白,更别说满足临床使用的工业化生产了。弗莱明的发现没能引起医学界广泛的重视,他也一直未能找到提取高纯度青霉素的方法,想要量产更是难于登天。弗莱明始终都没有放弃用青霉素治疗疾病的希望,为之做出了各种努力和尝试,但都不了了之。
10年后,1939年,德裔英国生化学家钱恩和澳大利亚裔英国病理学家弗洛里领导的溶菌酶和抗菌物质研究小组在各大图书馆查找以往文献的过程中,在一本积满灰尘的《新英格兰医学杂志》上意外地发现了弗莱明的这篇论文。他们立即把全部工作转到对青霉素的研究上来,成功分离出了青霉素粉末并把它提纯为药剂。1940年春天,经多次动物感染实验证明结果非常令人满意。于是,同年8月,钱恩和弗洛里等人把对青霉素的重新研究成果刊登在著名的《柳叶刀》杂志上。这篇文章极大地震动了弗莱明。年届6旬的他立即动身赶到了牛津,会见了30多岁的钱恩和40出头的弗洛里,并把自己培养了多年的青霉素产生菌送给了他们。利用这些产生菌,他们培养出效力更大的青霉素菌株。
1945年以后,青霉素遍及世界。
1945年,弗莱明、弗洛里和钱恩共获诺贝尔生理学及医学奖。全球开始正式进入抗生素时代。
(部分图片来源于网络,如有侵权请联系删除)